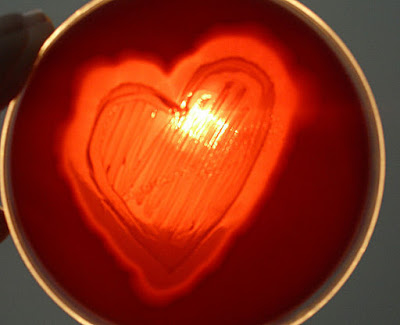

Ticker
6/recent/ticker-posts
Hot Widget
recent/hot-posts
Ad Code
News and Updates
20/MLS/slide-posts
Popular Posts
Labels
Messages
20/Message/grid-big
Random Posts
3/random/post-list
Contact UENR MELSSA
Popular Posts

WELCOME MESSAGE TO MELSSA – UENR FRESHMEN
March 02, 2021

Inside a Hospital Laboratory
February 12, 2021
Menu Footer Widget
Crafted with by TemplatesYard | Distributed by Gooyaabi Templates +233249583241

Social Plugin